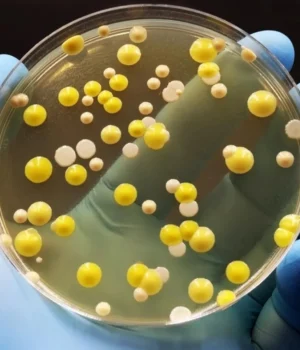

A higiene é essencial para itens do dia a dia que entram em contato próximo com o corpo, incluindo roupas, máscaras e escovas de dente. Os cientistas descobriram agora como o grafeno pode eliminar seletivamente as bactérias, deixando as células humanas intactas. Esta descoberta aponta para uma nova classe de substâncias antibacterianas que são seguras para os seres humanos e capazes de reduzir a dependência dos antibióticos tradicionais.
Recentemente, o KAIST anunciou que uma equipe de pesquisa colaborativa liderada pelo Professor Sang Ok Kim do Departamento de Ciência e Engenharia de Materiais e pelo Professor Hyun Jung Chung do Departamento de Ciências Biológicas identificou o mecanismo por trás das propriedades antibacterianas do óxido de grafeno (GO). Esse material possui uma única camada atômica de carbono com grupos de oxigênio, o que lhe confere a capacidade de se dispersar bem na água e desempenhar diversas funções.
Até agora, os cientistas não entendiam completamente como o grafeno alcançava o seu efeito antibacteriano. Este estudo fornece evidências claras em nível molecular que explicam como o material funciona.
A ação antibacteriana seletiva foi elucidada
Os pesquisadores descobriram que o óxido de grafeno possuía o que descreveram como “atividade antibacteriana seletiva”. Ele se liga e rompe as membranas bacterianas sem afetar as células humanas. O processo é semelhante a como um ímã adere apenas a certos metais.
Essa seletividade vem dos grupos contendo oxigênio na superfície do óxido de grafeno. Esses grupos se ligam especificamente a uma molécula chamada POPG, que é encontrada nas membranas celulares bacterianas, mas não nas células humanas. Simplificando, o óxido de grafeno detecta uma característica única das bactérias, liga-se a elas e perturba a estrutura celular. Os fosfolipídios constituem as membranas que circundam as células, e o POPG é um tipo encontrado principalmente em bactérias.
Eficaz contra superbactérias e promove a cura
Quando aplicado na forma de nanofibras, o material foi capaz de inibir o crescimento de uma ampla gama de bactérias nocivas, incluindo superbactérias resistentes a antibióticos. Testes em animais também mostram que ajuda as feridas a cicatrizarem mais rapidamente, sem causar inflamação.
Outra vantagem é a durabilidade. As fibras feitas de óxido de grafeno retêm suas propriedades antibacterianas mesmo após lavagens repetidas, sugerindo um forte potencial para uso em roupas, tecidos médicos e outras aplicações práticas.
Da descoberta em laboratório aos produtos do mundo real
Essa tecnologia já está sendo utilizada em produtos de consumo. Uma escova de dentes antibacteriana de grafeno desenvolvida através de uma patente da startup ‘Materials Creation Co. Ltd.’ liderada por professores, vendeu mais de 10 milhões de unidades, demonstrando forte sucesso comercial. Além disso, o GrapheneTex, um material têxtil que incorpora esta tecnologia, foi utilizado nos uniformes usados pela equipe de demonstração de taekwondo nas Olimpíadas de Paris em 2024. Também se espera que apareça em roupas esportivas funcionais em grandes eventos, como os Jogos Asiáticos de 2026.
Expandindo aplicações além do vestuário
“Esta pesquisa é um exemplo da descoberta científica de por que o grafeno pode matar bactérias seletivamente e ao mesmo tempo ser seguro para o corpo humano”, explicou o professor Sang Ok Kim. Ele acrescentou: “Usando este princípio, podemos expandir além de roupas seguras sem produtos químicos agressivos para uma gama infinita de aplicações, incluindo dispositivos vestíveis e sistemas têxteis médicos”.
Sujin Cha (Programa de Doutorado, Departamento de Ciência e Engenharia de Materiais) e Joo Yeon Chung (Programa Integrado de MS/PhD, Departamento de Ciências Biológicas) contribuíram como primeiros autores. O professor Hyun Jung Chung foi co-autor correspondente. As descobertas foram publicadas em 2 de março na revista Advanced Functional Materials.
A pesquisa também atraiu a atenção da Nanowerk, uma plataforma global de nanotecnologia, que a chamou de “destaque” sobre como “o óxido de grafeno destrói bactérias sem danificar o tecido humano”.
Apoio e financiamento à investigação
Este trabalho foi apoiado pelo Programa ‘Nano/Materiais Technology Development (R&D)’, Programa ‘Pesquisa Básica Individual’ e ‘Programa de Apoio ao Pesquisador em Meio de Carreira’, financiado pelo Ministério da Ciência e TIC.